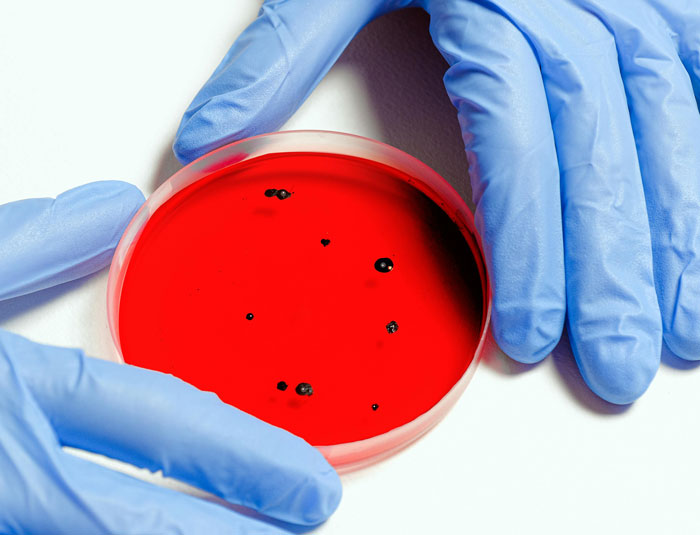
Doctor's Son Doesn't Understand Diseases.

“Stories About Kevin”: 30 Stories About People Who Are Depriving Some Village Of Their Idiot
InterviewStand-up legend George Carlin once said: "Think of how stupid the average person is, and realize that half of them are stupider than that." Stupidity, of course, is relative; what one person deems common sense can be a revelation to another. But that's the beauty of the human experience, isn't it?
On the Internet, sometimes we call those kinds of people who make questionable choices "Kevins." The folks at the "Stories About Kevin" subreddit share their humorous encounters with Kevins and Kevinas that would probably put your personal experiences with dumb people to shame.
To know more about the community, Bored Panda reached out to the moderators of the community. One of them, u/Nightcrawlerben, kindly agreed to chat with us about the subreddit's popularity and where we should draw the line between poking fun and cruelty. Read their thoughts below!
This post may include affiliate links.
That Time Kevin Thought He Could Understand Chinese
 Pretty sure my sister is a Kevin. There are at least a dozen stories like this.
Pretty sure my sister is a Kevin. There are at least a dozen stories like this.
We were out to eat at a Chinese restaurant, and the waitress, who was Asian, came up to us and asked us what we would like to order in English. Kevin looks shocked and doesn’t even wait for the waitress to leave as she loudly proclaims, 'I understood everything she said!
My family looks on at her in utter disbelief as my mom explains to her that’s because she spoke in English.
Kevin, The Horrible Housemate
 I used to live with a Kevin. He did so many stupid things that I can't possible mention all of them, but here's a selection:
I used to live with a Kevin. He did so many stupid things that I can't possible mention all of them, but here's a selection:
Kevin was allergic to strawberries, nuts and tomatoes but still ate strawberries, nuts and tomatoes.
He was also diabetic but once went on a several hour long hike in the wilderness without any of his medicine or any snacks. He didn't tell us until his blood sugar became so low that he almost passed out, and then we had to scramble for berries that he could eat while one of us had to RUN to get help.
He once put stuffed armchairs outside and was surprised when they were ruined eight months later.
He didn't know you had to clean a toilet. He was just surprised that his was grimy and dirty while everyone else's was not.
One time the electricity suddenly went out. It was Kevin's fault. He had tried to fix his computer with a scalpel. I still to this day have no idea what he was trying to achieve with a damned scalpel. We fixed the electricity and told him to stop playing with death. An hour later the electricity went out again. Any guesses why?
Anyway, he's now an architect who's responsible for actual houses.
Kevin Baffled By McDonald's Menu
 So my brother Kevin used to work at McDonalds. On his very first shift he was starting at the menu board absolutely baffled on and off for about an hour.
So my brother Kevin used to work at McDonalds. On his very first shift he was starting at the menu board absolutely baffled on and off for about an hour.
Eventually his manager came and asked him what was up and Kevin responded with "what's A.D.D bacon?"
The manager looked baffled for a moment apparently before bursting out laughing, "you mean add bacon? Like add bacon to a burger?"
Kevin having a lightbulb moment finally go off in his head was like "ohhh it's the word add hahahaha thanks"
He came home and proudly told everyone this funny story
There are no silly questions, especially when you're young. We've all had days when our brains just don't want to play ball!
The "Stories About Kevin" community describes a "Kevin" as a person "who consistently or greatly shows a complete lack of intelligence through incompetence of social and societal norms, or is purposefully antagonistic in their poor decision making."
Stories with small, understandable mistakes have no place in "Stories About Kevin." "If they misspell a word, or make a simple mistake, they are not a Kevin," the group's rules read. "They dropped something? Not a Kevin." Stories about people being rude or inconsiderate don't exactly fit either. A person has to be lacking intelligence to truly be a Kevin.
Kevins On The Wildlife Hotline
Heya everyone! Just for context, I’m a hotline worker for my state’s wildlife hotline. Which means I get to see a LOT of interesting people. Here’s some of the most interesting stories that I can think of. These are multiple Kevins, not the same one btw!
Kevin found that his cat caught a bunny. Kevin contacted us to ask where to take it. Upon being told the closest rehabber was 20 minutes away (which is pretty good!), Kevin said he would call an ambulance for the bunny. A human ambulance. Kevin was advised that is not a good idea and we got the bunny from him instead.
Kevina is a new mom, who finds what she thinks is a baby opossum, who she says is probably too small to be on its own and needs milk. Kevina then explains that she can care for it because she’s breastfeeding, and she breastfed it as well. She sends us an image of the animal. It is an entire, very confused, rat. A wild rat. We took the rat from her. Rats bite. Rats are fast. I still don’t know how that happened.
Kevin contacts us about an injured hawk. Asks what they eat because it ‘looks hungry’. Advised to take hawk straight to rehab, instead of feeding. Kevin says he will give the hawk his recipe of mashed potatoes, because it helps him when he’s sick. Proceeds to get offended that we don’t believe in his mashed potatoes. Proceeds to get offended that the hawk doesn’t believe in his mashed potatoes either.
Opossum brought into rehab inbetween two pieces of bread. Bread was ‘in case he got hungry’. Kevina brought in a possum sandwich.
Kevina spams us about an abandoned baby squirrel, too small to be on its own. She caught him and is keeping him to give to a rehabber. Sends us an image. It is an adult chipmunk. Advised that it was, in fact, a normal chipmunk. I was then educated that chipmunks are just baby squirrels, and that I should respect my elders. Advised her to let the chipmunk go, which she did.
Kevina contacts about baby bears. Says she doesn’t see mom, so she’s going to ‘rescue’ them. When told to not do that by any means, she argued that she knew best. She sent an image 10 minutes later of momma bear with cubs, staring at her. Mom “came out of nowhere” when she tried to pet one. Nobody was hurt, miraculously
Kevin contacts us about 8 baby hamsters that seemingly appeared to him miraculously. When informed we are a wildlife hotline, Kevin argued that hamsters are wildlife because there’s wild hamsters somewhere in the world. Told Kevin to take to a rodent rescue close to him. Kevin argued that hamsters aren’t rodents, they’re mammals.
I’m sure there’s more, but here’s some off the top of my head. These are just a few over my first year, most people are lovely, so don’t lose your hope in humanity just yet. All of the animals here either were fine or got into care, and as far as I know they’re all healthy and fine now. If you find injured wildlife, please contact your local wildlife rescue or wildlife hotline, if there is one. If you have any questions, let me know!
My Friend's Wife Is A Kevin
 My friend's wife is a Kevin. He told his wife about an article he read about people in Siberia digging up frozen mammoth tusks and selling them.
My friend's wife is a Kevin. He told his wife about an article he read about people in Siberia digging up frozen mammoth tusks and selling them.
Her: 'That's terrible!'
Him: 'Why is it terrible?'
Her: 'They'll sell all the frozen ones and then people will start killing mammoths for their tusks, and pretty soon they'll all be extinct!'
Kevina Can’t Read Gas Gauge
 I think my best friend may be a Kevina.
I think my best friend may be a Kevina.
Recently I went to visit my friend and spend a week with her and her parents at their lake house. She picked me up from the airport and we drove several hours to get to the lake house. I remember having a fleeting thought on the drive that we have to be getting low on gas due to the sheer amount of time we were driving. I brushed it off and we made it to our destination no problems.
The next morning her dad asked for the keys so he could drive to town to pick up groceries. He left and came back two minutes later stating that the car didn't have enough gas for the 10 minute drive to town. He also asked Kevina how we made it all the way from the airport without getting gas.
I kid you not, Kevina looked her dad straight in the eye and said, "Dad what do you mean? The car has a half tank. I checked multiple times since we left the airport and it's still sitting half full."
Her dad, completely dumbfounded, looks at her and says, "Jesus Christ, you were looking at the oil temperature the whole time weren't you?" Spoiler alert, she was. She thought the oil temp gauge was the gas gauge and didn't notice the blaring low gas light at any point in the drive.
That reminded me of a post I saw somewhere: someone had posted a pic of the oil warning light & asked what it meant. The first response was "You have 3 wishes" oil-pressu...53c524.png 
To find out more about the subreddit, we messaged one of the community's moderators, u/Nightcrawlerben. They were posting stories about the Kevins they met on the subreddit 10 years ago, so, we were curious to know what, in their opinion, draws people to such a community.
"I think people share stories about Kevins they have encountered in their life because they have found some enjoyment or entertainment from it," u/Nightcrawlerben tells us.
"Personally, I've had a pretty interesting life up until this point and I've shared these stories with friends [who] tell me all the time how this could be a story from Reddit. So, I decided to post them and read other people's experiences. It's nice to know that people can relate even when your life is going in a crazy direction."
Kevina The Sandwich Artist
 Kevina’s mother runs a Subway fast food franchise that my friend frequents with his partner and daughter. For reasons that are not entirely clear, teenage Kevina got kicked out of school. To help her occupy her time, Kevina is now a trainee 'sandwich artist' at her mother’s Subway franchise.
Kevina’s mother runs a Subway fast food franchise that my friend frequents with his partner and daughter. For reasons that are not entirely clear, teenage Kevina got kicked out of school. To help her occupy her time, Kevina is now a trainee 'sandwich artist' at her mother’s Subway franchise.
My friend, his partner, and his daughter usually buy one footlong sub and ask to have it cut into thirds so they can share it. Usually, that isn’t a problem, but this time Kevina was serving them. She assembled the sub (doing a pretty poor job of it) and then cut it in half. Her mother/supervisor told her to do it again.
So Kevina assembled another sub, and proceeded to cut it into quarters. At this point, my friend was covering his mouth as it gaped in disbelief. Kevina’s mother/supervisor explained to her that cutting the sub into quarters won’t help when the customer wants to share it between three people.
Unperturbed, Kevina took away one quarter of the sub and said, 'OK, now they can share it between three people!' Her mother/supervisor attempted to explain that a customer won’t be happy if they don’t get the whole sub they paid for.
We’re now wondering about two things:
Firstly, how does someone make it to their teens without understanding fractions?
Secondly, was the real reason Kevina got kicked out of school due to frustration with incredibly poor academic performance?
It's completely understandable to accidentally cut the sub in half, as that's how the always do and probably was done before even thinking. But the rest is pretty dumb.
The Cart-Before-The-Horse Kevin
 In my school, we had to do about six to eight months of social service before graduation. I — being an edgy teenager — decided to do mine in a funeral home. [Kevin] confessed to me he wouldn't have the guts to work at a place where they kill people.
In my school, we had to do about six to eight months of social service before graduation. I — being an edgy teenager — decided to do mine in a funeral home. [Kevin] confessed to me he wouldn't have the guts to work at a place where they kill people.
Kevina Gets Fired
 I worked with a vet tech Kevina. Worked, as in the past tense, because she got herself fired. One day, she was hanging out with her dog and started laughing at something. Her dog jumped up and licked her tongue. That night, Kevina started having diarrhea. She decided that the only possible explanation was that she got worms from her dog's unexpected French kiss. The next day at work, she pulls some dewormer off the shelf and takes an unknown amount. This isn't terribly stupid by itself, but what sealed her fate was that she was openly bragging about it to the other technicians. Literally nobody would have known, but she must have been so proud of her idea, she couldn't stop telling people. Eventually, she comes across our manager and tells her all about her genius plan. My manager was aghast and was forced to fire her basically on the spot for stealing medication from the hospital.
I worked with a vet tech Kevina. Worked, as in the past tense, because she got herself fired. One day, she was hanging out with her dog and started laughing at something. Her dog jumped up and licked her tongue. That night, Kevina started having diarrhea. She decided that the only possible explanation was that she got worms from her dog's unexpected French kiss. The next day at work, she pulls some dewormer off the shelf and takes an unknown amount. This isn't terribly stupid by itself, but what sealed her fate was that she was openly bragging about it to the other technicians. Literally nobody would have known, but she must have been so proud of her idea, she couldn't stop telling people. Eventually, she comes across our manager and tells her all about her genius plan. My manager was aghast and was forced to fire her basically on the spot for stealing medication from the hospital.
There's a fine line between poking fun at someone for acting silly in a harmless way and being malicious and mean about it. When we brought this up to u/Nightcrawlerben, they admitted that some of their posts come across as insensitive today even to themselves.
"I haven't posted in about 10 years and decided to look back on my posts earlier today. Most of my posts were from 10 years ago, it's interesting to read what I had posted, and the lingo I used. I would not post things with the same vocabulary choices as I did 10 years ago."
I’m Married To A Kevin
 Oh the stories I have, I think my husband could be the king of all Kevins. One of my favorites is when he wanted to remove his back hair but no one was around to help. His great idea was to get Nair body hair remover, spread it on the bathroom floor, and lay in it.
Oh the stories I have, I think my husband could be the king of all Kevins. One of my favorites is when he wanted to remove his back hair but no one was around to help. His great idea was to get Nair body hair remover, spread it on the bathroom floor, and lay in it.
I can picture all 6’4”, 300+lbs of him doing Nair angels in our bathroom.
He gets in the shower, rinses it off, and then goes about his day. He went to a work appointment, worked out at the gym, then picked up the kids from school. While walking out, our son asked why he had a bald spot on the back of his head.
OMG, he got Nair in his hair and had a perfect bald 3 shape on the back of his head. After a few more days, more hair fell out, and it was a perfect 8.
My Sister The Kevin
 I found this subreddit and it’s perfect for my sister. I lived with her for 16 years and had to babysit her (despite being younger) for all of those (we are both adults now so she’s on her own). Let me go down the list of some of her greatest hits:
I found this subreddit and it’s perfect for my sister. I lived with her for 16 years and had to babysit her (despite being younger) for all of those (we are both adults now so she’s on her own). Let me go down the list of some of her greatest hits:
She got MRSA because the house she was living in ran out of toilet paper and thought the next best thing to use was the BATHROOM CLEANING SPONGE
A few years prior to that incident she got a very infection downstairs because once again ran out of toilet paper and thought it would be okay to use a wash cloth…. Which is fine once but she used the same one continually so she wouldn’t have to buy more toilet paper
She got her drivers license confiscated at a chuck E. cheese because she went to get a gift card there and they asked if she was there to pick up a kid (she has no kids), she panicked and said yes for some reason and they said they needed her id until she returned with her kid and showed them a code. She obviously had no code and wandered aimlessly for a bit, panicked when someone asked her if she needed help, and then ran out while crying. She never got the id back.
She somehow got s**t on the ceilings when she had diarrhea
She complimented someone’s shirt and they jokingly said “thanks you can have it” and she then asked “so should we go to the bathroom and trade?” And the girl looked horrified.
There’s more but this is all I can think of for now. She recognizes that she does weird things and always prefaces her stories with “So I did something really embarrassing today”
Kevin Learns About Bees
 When I was in eighth grade, my teacher struggled mightily to convince a Kevina that bees are pretty much normal insects, but when they sting you, they’re injecting a toxin that hurts as a defense mechanism.
When I was in eighth grade, my teacher struggled mightily to convince a Kevina that bees are pretty much normal insects, but when they sting you, they’re injecting a toxin that hurts as a defense mechanism.
Kevina did not believe her. Instead, she thought that bees buzzed because they obviously contained electricity, and the sting was, therefore, actually an electric shock.
u/Nightcrawlerben says that intentions matter a lot in this case. "Ultimately, I think it's okay to poke fun at ignorance, especially if it's something we can all relate to," they tell us. "We all have a friend who is constantly ignorant [of] the situation, but, in the end, we still care about that friend."
Kevina Doesn't Know About Autumn
 I am currently training to be a gardener and I am in a class with a real Kevina. I could tell many stories and I kind of feel bad for her sometimes, because she has a hard time understanding basic things and apparently was never taught the most basic things. She basically on an intellectual level of a 12 year old while she is actually 26.
I am currently training to be a gardener and I am in a class with a real Kevina. I could tell many stories and I kind of feel bad for her sometimes, because she has a hard time understanding basic things and apparently was never taught the most basic things. She basically on an intellectual level of a 12 year old while she is actually 26.
One day 8 months into the course, while revisiting all the material we had learned for the final exam of that year with our teacher, she asked out of the blue why all the trees lost their leaves in the winter and had to be felled. Turns out that by that time she had never understood that some trees drop their leaves in winter and grow new ones in spring (we were obviously taught as much) and she seemed to confuse pruning with cutting down a whole tree (we had a whole exam about all the possible ways to prune trees)
There are more examples of her not understanding basic concepts even after hours and hours of our teachers explaining them to us but that one left me speechless
Kevin Thinks He’s A Shopping Genius
 This story dates back about ten years but I recently remembered it and thought you guys might enjoy.
This story dates back about ten years but I recently remembered it and thought you guys might enjoy.
I worked retail at the time, Gamestop to be exact, so you might be able to guess what kind of guy Kevin was.
He was never abusive to the staff but he was super annoying. Honorable mentions: - tried to negotiate prices on brand new, AAA titles - spent hours hanging out at the counter, chatting up staff and other customers - tried to hit on all female staff memebers - tried to convince male staff members to be wing man in above attempts - tried to go into the back room to find something because “he was a friend of the house and could do that”
Eventually Kevin was told that he was no longer welcome and we would refuse service if he did come back unless he had seriously changed his behavior.
About two weeks go by and then Kevin walks into the store. We were three staff at the store, me, co-worker and manager. Manager was in the back, we were in front.
My co-worker politely but firmly tells Kevin that he is not welcome. Kevin acts totally surprised and proceeds to try to tell us that we must have him confused with someone else! He insisted he had never been to this store before, never seen any of us before, his name wasn’t Kevin (he called himself Kelvin instead).
With none of his arguments working, Kevin became frustrated his brilliant plan wasn’t working and then uttered the words “Well, you need to get [manager’s name]! He knows me!”
Yeah, manager was not impressed either and told him to leave as well.
I Married A Kevin Who Chews Up Non-Chewable Vitamins, Among His Many Other Kevinisms
 I have considered whether I married a Kevin. He has done things in the past that made me wonder. I was told when he was a boy that his mom gave him money to go to the store to buy her a bunch of bananas, as in one bunch. He thinks a BUNCH of bananas. She apparently was giving bananas away, making banana bread, and banana puddings for quite some time afterwards.
I have considered whether I married a Kevin. He has done things in the past that made me wonder. I was told when he was a boy that his mom gave him money to go to the store to buy her a bunch of bananas, as in one bunch. He thinks a BUNCH of bananas. She apparently was giving bananas away, making banana bread, and banana puddings for quite some time afterwards.
When he was learning to drive, his dad told him he was going to be turning right at the next road. It was a red light and he thought “Why should I wait in the line for the light to turn when I can just cut through the median and be on my way?”
Shortly after I married him, I caught him one night with a canister of instant hot chocolate picking things out of it and looking concerned. I asked him what he was doing and he informed me there was dried up corn kernels in our hot chocolate. I went to look for myself. It was the freeze dried marshmallows. When I made my discovery, I asked him why it didn’t occur to him that it wasn’t it wasn’t corn because 1. They were white and 2. They weren’t shaped like corn. He said he didn’t think marshmallows would look like that.
A little later we had a couple cats and a dog. He fed the cats the dog food because we were out of cat food. I guess it didn’t matter much because they are similar animals. When I told him I could have bought cat food since I was out, he was then worried he accidentally killed the cats.
Just tonight my poor little Kevin decided he wanted a magnesium supplement for his sore muscles because I take them when my muscles are hurting. He pops it in his mouth and starts munching it down. He grimaces and tells me that it tastes awful. I wasn’t paying attention until I heard the sounds of revulsion and look up to see the awful look on his face. I couldn’t help but laugh and tell him you’re not supposed to chew it! He said “But some of the vitamins ARE chewable!” Yeah but not all of them lol.
A few minutes ago when I was still giggling about it I asked him why he didn’t spit it out or at least finish it off by swallowing it with a drink of water. He said he already started it out that way so he might as well finish it that way.
My poor little Kevin.
My partner & I are howling over the hot chocolate bit!! He is now going to apply that logic to everything in life "Doesn't look like 'X', so it must be corn 🤷♀️" 🤣🤣🤣
The mod also believes people should keep in mind that there's a thin line between poking fun and cruelty. "We aren't out to make fun of people with malicious intent or talk about situations that are cruel. We just want to share stories that could have been frustrating at the time, but we've since then calmed down and shared the story for others to enjoy," they explain the subreddit's philosophy.
My Mil Was A Kevina
 My MIL (God rest her soul) was a quintessential Kevina. To call her "technologically challenged" would be a compliment. I'm not talking about the stereotypical "Why is my computer slow when I have 85 Chrome tabs open." (TBH, I never trusted her to own a computer.) Her problems were much more basic.
My MIL (God rest her soul) was a quintessential Kevina. To call her "technologically challenged" would be a compliment. I'm not talking about the stereotypical "Why is my computer slow when I have 85 Chrome tabs open." (TBH, I never trusted her to own a computer.) Her problems were much more basic.
She called me one day saying that her TV stopped working after a power outage. Now, she understood enough to know the TV would not work without power, but after the power came back on, the TV didn't. I went to her apartment, grabbed the remote, and hit the power button. the TV instantly came on. She never tried to turn it back on. She just assumed that it would come back on when the power did. A similar situation happened with her cell phone (a basic flip phone.) I hadn't heard from her in a few days, which was unusual. My wife and I went to check on her, and she told us that her phone battery died, and hadn't worked since. Once again, she knew it wouldn't work without a battery, and had fully charged the phone, but, once again, she had not even tried to turn it on. I hit the button and it powered right up. I tried getting her an iPhone because it automatically powers on when plugged it, but, no matter how many times I explained it, she could not understand the concept of a touch screen.
It wasn't just electronics either. She owned and drove a car, and the fact she never got into an accident was a major miracle. She didn't learn how to drive until her husband died when she was in her 50s. Before that time, she had never even pumped gas. The entire 10 years she drove, she never made a left turn. Ever. She would drive miles out of her way just to avoid a left turn, light or no. She never used blinkers because they "made a weird clicking noise." I got a call from her one day that she could not see anything at night. I had to show her how to turn on the headlights. (I know that some modern cars have automatic headlights, but she only ever drove one vehicle, and it never had this feature.) Another time she complained that the AC in her car wasn't working. It only blew hot. I fixed it by turning the dial from red to blue. We eventually stopped letting her drive, and the world was safer for it.
She bought a NutriBullet from an Infomercial for $150, and it sat in the original box unopened for a year and a half. When asked why she never used it, she said she didn't know how. After a year and a half, she bought another one for $250 because "this one comes with recipes!" She never used that one either.
She ended up dying from typical old-person type stuff in her 70s. The fact that she didn't die doing something ignorant is a miracle!
Aw, bless her. She sounds like my MIL. Lovely woman who can sew, knit, decorate, arrange flowers, and all that stuff to rival any high-end professional, but anything to do with basic electronics, forget it! And driving? She herself will laugh it off and say that she's lived along the Merseyrail lines all her life & never really needed to learn but I'd only recommend getting in the car with her if you want to know what constant sweating & heart palpitations feel like 😱 lol.
Kevin Thinks States Are In Different Months
 So a few co-workers in a different department than mine were talking together and one brings up how there is already snow in Idaho. One of them shows the other a photo on their phone and says, 'I can't believe there's already snow in Idaho. It's October!'
So a few co-workers in a different department than mine were talking together and one brings up how there is already snow in Idaho. One of them shows the other a photo on their phone and says, 'I can't believe there's already snow in Idaho. It's October!'
Now, Kevin is within earshot of this conversation and decides to chime in.
'But it's not October in Idaho yet...'
Kevin thinks states are in different months.
The other two are just flabbergasted and it takes them a moment to process what they just heard before they can tell him how wrong he is.
Recent Occurance
 I have a Kevin I work with who I would call dumber than a sack of hammers, but that would be rude to the hammers.
I have a Kevin I work with who I would call dumber than a sack of hammers, but that would be rude to the hammers.
Fairly recently at work, Kevin was approached by a customer and asked what aisle tampons are in. Not only did he not know what they are (mind you he has multiple sisters and mom is still in the home), but he proceeded to approach a teenage girl and her Dad to ask what tampons are and how you use them.
To make matters better/worse, I should also mention that he thought tampons are a type of soap.
I have more stories of this particular Kevin if y'all are interested in hearing them. This one just happens to be my favorite at the moment.
As a moderator, it's one of u/Nightcrawlerben's duties to make sure there's no mean-spirited comments, harassment, and other negativity in the subreddit. "We will make [a] comment or DM the OP and either have them adjust the post or we will delete the post and give the OP a warning," the mod shares how they deal with inappropriate comments.
My High School Friend, The Most Dangerous Of All Kevins, The Book Smart One
 She was incredibly book-smart. Maths, chemistry, biology — absolutely spot on, straight As. She struggled with physics and English, and it puzzled her teachers as the skills she needed to pass she could obviously utilise given her grades in other subjects.
She was incredibly book-smart. Maths, chemistry, biology — absolutely spot on, straight As. She struggled with physics and English, and it puzzled her teachers as the skills she needed to pass she could obviously utilise given her grades in other subjects.
The highlights from our time were:
— She put tinfoil in the microwave, and it caught fire. She put the microwave in the kitchen sink and turned on the tap to put the fire out. While it was still plugged in.
— She was having trouble with geography and the teacher was trying to explain and failed. Eventually, the teacher resorted to basics and asked her to point north. Kevina pointed to the ceiling.
— If you asked Kevina directions, she'd have to hold her hands up to 'look for the L for left.' Fair enough, a lot of people struggle with that and use that trick. Kevina would do it with her palms facing her.
— We watched a movie together once, and about halfway through, I realised she shared her name with the main actress and pointed it out. Her reply: 'Really?! What's her name?!'
Girls withh ADHD/ADD or those on the autism spectrum though high-functioning, are often not diagnosed because they have those abilities that make others think they should be good at everything. Fake it till you make it was one of my mottos in school. I was expected to get good grades in everything because I was smart. I learned a lot of tricks to get around barriers in education. But I never learned I was on the autism spectrum until my granddaughter was identified, and subsequently my son.
World’s Dumbest Doctor
 I worked with the dumbest doctor I’ve ever met. He was dumb, socially inept, lazy, a complete narcissist, and not particularly good at keeping himself clean. He truly had no redeeming qualities. Not going to give identifying details or name his specialty, but here are his top five “accomplishments”, starting with the least bad:
I worked with the dumbest doctor I’ve ever met. He was dumb, socially inept, lazy, a complete narcissist, and not particularly good at keeping himself clean. He truly had no redeeming qualities. Not going to give identifying details or name his specialty, but here are his top five “accomplishments”, starting with the least bad:
1: Getting lost on the way back to the unit
2: Asking WHERE the parking garage that had been under construction for months was. Not “when’s the garage opening?” or “How do I get into the garage?”; just….”Where’s the garage?”
3: talking about military history and insane pet ideas (Benedict Arnold had to commit treason because the Army wasn’t paying him enough!) instead of seeing patients
4: making insane medical decisions (not exactly what happened but think of something like putting a patient without cancer or autoimmune disorder on chemotherapy)
5: wearing other doctors’ white coats, with their names embroidered on the coats. When I suggested getting a coat with his name on it, or at least covering up the other names, he chose to cover the name….WITH CLEAR TAPE.
Sorry but this person doesn't sound healthy. If an actively working doctor sounds exactly like my alzheimer's suffering 80-year-old grandma, there is sonething really wrong.
Kevin Blames His Wife For Only Having Girls. Mommy Had To Tell Him How It Works
 I 30 F have 2 daughters and am currently pregnant with my 3rd girl. We just found out this morning. On the drive to my husband’s mothers house he explained how he was a bit disappointed about having a girl. But then he said “I should’ve expected this because you have 3 sisters”
I 30 F have 2 daughters and am currently pregnant with my 3rd girl. We just found out this morning. On the drive to my husband’s mothers house he explained how he was a bit disappointed about having a girl. But then he said “I should’ve expected this because you have 3 sisters”
I explained that me having 3 sisters have nothing to do with the gender of our child. He said it’s genetics and that I’m the reason for our daughters. I told him that’s not how biology works, he said it is.
He then went on the explain that his mom only has brothers and his two oldest brothers both have two sons because his mom’s side. I told that doesn’t make any since because it should be the same for him then. He said no because both of their wives have more brothers than sisters.
He was getting frustrated but I was just laughing at him. I explained that him and his oldest two brothers have different dads, but out of his dad’s 8 kids, 3 are boys and 5 are girls. The men determines the gender.
He said that not true because the kids his dad had with his mom are all boys. He dropped it and said he’ll ask his mom who has a degree in biology.
So we get to his parents house for brunch and he asks his mom if I’m the reason we kept having girls. She told him bluntly that the men determines the gender and it’s actually not a 50/50 chance. She then went on to explain that the more of one gender you have, the higher the chances that your next child is also going to be that gender.
So he asked is it likely that he’ll have a boy. She told him that if he keeps trying it might happen. He just walked to the car and said he’s going for a drive. I received a text from him saying that I didn’t have to embarrass him like that. I was so confused. Aita?
We were curious to know the story of the subreddit's inception. "I believe there was a different community where someone was posting content that people liked with the main person being called 'Kevin,'" u/Nightcrawlerben says. "Those stories became pretty popular and r/StoriesAboutKevin was born."
I Had My Own Kevin Moment
I was searching for my phone earlier today and asked Siri to call my phone. My phone began to ring and it was in my hand the entire time. I feel dumb.
I feel like everyone's done something similar to this at some point
Boss Kevin Doesn't Understand Workplace Hazards
 About a year ago, I was training to be a machine operator in a food processing plant. Kevin was the supervisor. One day, a forklift's rear-view mirror broke off and shattered next to one of the machines. Kevin swept up the glass, and then proceeded to swing the bag containing said glass over his head in a circular motion. When confronted, he said "I was told the mirrors were plastic", completely oblivious the the fact that the contents of the bag were still sharp. It's a goddamn miracle he didn't injure himself or anyone else after that stunt. A few months later, Kevin was moved to a different position due to creating a hostile work environment.
About a year ago, I was training to be a machine operator in a food processing plant. Kevin was the supervisor. One day, a forklift's rear-view mirror broke off and shattered next to one of the machines. Kevin swept up the glass, and then proceeded to swing the bag containing said glass over his head in a circular motion. When confronted, he said "I was told the mirrors were plastic", completely oblivious the the fact that the contents of the bag were still sharp. It's a goddamn miracle he didn't injure himself or anyone else after that stunt. A few months later, Kevin was moved to a different position due to creating a hostile work environment.
I was called one day to fix a cigarette machine. According to the manager the machine had "gone crazy" and was dispatching the wrong brands. i.e you pressed for camels and Marlborough came out. I asked if she had refilled the machine correctly and she was adamant that she had. Turned out that she had just put all the different brands in nilly w***y even mixing brands in the same columns. She was convinced that the machine KNEW what packet to dispense.
My Husband And The Tools
 Kevin and tools do not mix
Kevin and tools do not mix
So this is a story about my husband, let's call him Kevin. My husband, 37 year old, is the most wonderful and kind person I know but what made me marry him is the fact that he makes me laugh a lot without trying.
We have two twin boys and that was about 1 years old when this happened. We were going to the doctor for a appointment, as they are premature babies we had a lot of doctor visits at this time of their lives. And as all you parents put there will know, babies keeps you busy and always late to everything! My darling husband was annoyed with me because I was sure taking my sweet time. No this was not because I'm a woman that's always late. This was because no matter how much I tried my bag would not come with me and then it hits me: A few days prior the hook and basket storage shelving system in our entryway had fallen down. This is where we keep gloves scarves etc, and my number one bag always hung on this thing. A normal person when asked to fix this issue would of course empty the storage unit but not my husband. So now I stand there trying to bring my precious wonderful bag with me but that thing was stuck on the wall along with the unit and blocked with screws. And no i could not just take a new bag as this was the bag with ALL our baby stuff in it, so wasnt the best timing for this issue. Got to say he did a good job putting that unit back up though. So in a hurry to the doctors my sweet husband has to unscrew this thing to free my best friend from its prison and while I stand there I look at my sweet wonderful angel baby boys and thinking to myself " My god how will this go for them with a father like Kevin?"
This is just one of so many stories about my husband. No he is not dropped behind a wagon in full speed, he Is actually really smart but he does have a way to go into his bubble a lot where no one can reach him. But it sure gives me a lot of stories to tell.
What on earth was this person trying to describe? A diaper bag tangled in a broken down storage shelf? "The bag would not come with me because it was blocked with screws?" I think this household contained two Kevins.
There's a paradox about people perceiving how smart they are: the more intelligent you feel, the dumber you actually are. It's called the Dunning-Kruger Effect. The two researchers, David Dunning and his grad assistant Justin Kruger, did an experiment in 1999 with undergraduate students. They found an interesting phenomenon: people who are less competent at something usually tend to overestimate their capabilities, and vice versa.
The (Overly) Cautious One
This took place over a decade ago, when I was 17. I was getting my A Levels from a high school in India (I’m Indian). There was this Kevin who was a part of our group. Very funny guy. He had a lot of non-Kevin moments as well. But most of the time, he was a complete Kevin; I can’t be sure if he was playing dumb for laughs or just really dumb at times.
At that time, the [emergency contraceptive] pill that was easily available cost like 2.50 USD, was called something like 'Pill 72,' and had two pills in it. The first pill had to be taken within 72 hours of sexual activity and the second had to be taken 12 hours after the first. So we all knew that because it was mentioned in the little booklet that came in the box.
Well, one day, Kevin and his girl lost their virginities to each other. Of course, they used no protection at all. Kevin and his girl were at my boyfriend’s house, and we were all chilling. A guy from another couple bought the pill(s) for Kevin’s girl and handed them over for her to take.
Kevin, like the gentleman he was, opened the packaging for her, poured her a glass of water, and gave her a pill in her hand. Then, to our horror and amusement, he takes the second pill, pops it into his own mouth, and then proclaims 'done.'
It took us the next half hour to explain that he wasn’t supposed to take it; it was meant only for her. He still couldn’t understand. We made him read the booklet, we tried to find a video for him to watch. He was still unconvinced. It got to the point where someone ran down to get his girl another pill for her to take 12 hours later.
I heard he took the 2nd pill again, 'just to be safe.' In fact, the next time they used the pill, they bought two, and he took one set and she took the other. We tried to talk sense into the girl, and she said, 'Just go with it.'
The Tech Genius
 For a presentation, he wanted to print a video onto paper. When the printer finished printing just a screenshot of YouTube, he was almighty about, 'Wow the library printers sure are old, they can't print video yet.'
For a presentation, he wanted to print a video onto paper. When the printer finished printing just a screenshot of YouTube, he was almighty about, 'Wow the library printers sure are old, they can't print video yet.'
When I asked him what the f*** he was talking about, he mentioned that if we printed a video into our presentation the teacher would be more impressed. When I tried telling him that it was impossible, his response was, 'Dude, how do you think they do it in the Harry Potter movies then?'
I must have gone to the bathroom during the part in Harry Potter where they went to the library and printed a video for a presentation 🤔
Our Kevingellina Family Friend
 One day when I was ten my mother brought a Kevingellina to sleep over. In the three days she spent in our house she made some very interesting stupidities, but one really got me questioning how she functions as a human being.
One day when I was ten my mother brought a Kevingellina to sleep over. In the three days she spent in our house she made some very interesting stupidities, but one really got me questioning how she functions as a human being.
From the first moment she arrived she was claiming to have some pain in her eyes. She said she wasn't seeing well and I could confirm they were red and teary. So straight to the act, after some thirty minutes Kevingellina asks for painkillers and we had some pills at home, we kept around for occasional headaches. I gave them to her, thinking she was having a headache from the pain in her eyes. I then watched this lady GRIND three pills and SPRINKLE the powder into the inside of each lower eyelid. Her eyes got so sore and red I thought she would cry blood, but the lady remained calm and collected, as silent tears flowed from each eye. Didn't even wipe her nose which equally leaked.
I don't believe this one, specially the part where no one stops this person from dumping pill powder in her eyes.
Dunning went on to write a book called Self-Insight, in which he explained that what we call "smart people" have higher levels of metacognition: they analyze and judge their ideas, knowledge, and skills more. "If you're incompetent, you can't know you're incompetent… The skills you need to produce a right answer are exactly the skills you need to recognize what a right answer is," he wrote in Self-Insight.
I Think I'm A Kevina
 My country is a bunch of islands. In my late teens I tried to pat a seal because I thought they were cute sea doggos. It chased me back to the car, I think I almost died lol
My country is a bunch of islands. In my late teens I tried to pat a seal because I thought they were cute sea doggos. It chased me back to the car, I think I almost died lol
I didn't know what continents are until I was 27.
Got fired from my last job as a cook because I kept forgetting to turn the deep dryers off overnight.
I can't drive I keep getting the accelerator and brake confused and just crash.
Kevin And The Party
 Kevin (ex fiance) told me one Friday afternoon, after work, that we had a 21st birthday party to attend that night.
Kevin (ex fiance) told me one Friday afternoon, after work, that we had a 21st birthday party to attend that night.
We had both just finished up long shifts at our work, and he was getting dressed in jeans and a polo top.
I quickly brushed my hair, and threw on some jeggings, and a knit top, and we jumped in the car to head off.
I told him we cant just go empty handed, so we stopped to buy a bottle of wine, and a bunch of flowers on the way.
As we were getting closer, he asked me to get the invite out of the glovebox, and tell him the address.
It was at this point that I saw the very fancy invite, which stated the dress code was formal.
I said "Hey, this invite says the dress code is formal"
Kevin "Yeah I saw that"
Me " Ummm, we are not dressed for the party, we need to go back home and change"
Kevin "Nah, we are fine, and we are almost there"
He doesn't listen to me. He insists what we are wearing is fine 'its just a birthday party'. He also tells me that he got the invite almost 2 months prior, and had been meaning to tell me about it earlier, but forgot.
Long story short - we arrive at the venue - a very fancy ballroom type venue, in a prestigious club.
I am the ONLY girl not in a stunning floor-length gown, and he is the only man not in a tuxedo.
I was mortified and kept apologising. Kevin didn't seem phased by it all.
A few weeks later I heard that Kevin had told people that I had never told him it was a formal event, and that is why we turned up dressed casually.
Warehouse Kevin Aka "Cultural Wasteland"
Back in 2023 I worked in a medical supplies (bandages ect) warehouse for about 6 months. The place had a horrific turnover rate because management was terrible and the work paid terribly. we had quite a few people come and go some of whom may charitably have been described as not the highest calibre of professional. a year on though one sticks out the most, Introducing Kevin the cultural wasteland, God in his wisdom did not see fit to grant Kevin much cognitive ability. here is a selection all of which occurred in the 4-5 weeks he worked there
Kevin got in trouble multiple times for vaping in the middle of the warehouse when he thought nobody was looking, we had cameras, he knew this
Kevin got in trouble for doing wheelies on his motorcycle in the parking lot, he responded by saying "but I wasn't even Inside"
Kevin told me he once got in trouble during a hospital visit for a hand injury because his knee jerk response to pain is to say the N word, the hand injury was not work related
Kevin insists that he used to be a successful [substance] dealer and that he made enough money to have a house with no mortgage (he was like mid twenties) according to him he was only doing warehouse work because "I decided to get out of that life while I was ahead"
We had a Lithuanian forklift driver who used to say "Bon apatite" to anyone she passed while heading out to lunch, the first time Kevin heard this he turned to me and a group of other people and said, in all seriousness, with a curious look on his face "Is she speaking Lithuanian?". It is this incident that lead to the nickname "cultural wasteland" given to him by the boss man himself.
There was a McDonalds very close to the warehouse that people used to go to for lunch all the time, Kevin left for that reason one day and never returned, He obviously had decided he was done working there but legend says he is still trying to find his way back.
The reason the grammar Nazi below is irritating is because none of the mistakes made in post they're criticizing interfere with anyone's ability to follow the story. So Jay Cee just comes off as a pedantic nitpicking twat. It also doesn't help that Jay Cee made a grammatical error of their very own in their post. Personally, I find this quite hilarious.
Ultimately, haven't we all at one point in our lives overestimated our intelligence, skills, or knowledge? I know I definitely have acted like a Kevina once or twice. So, let's not forget that while we chuckle at these Kevins. And, if you're looking for more funny stories when you're done with this list, check out our previous article about the "Stories About Kevin" subreddit here!
Kevin Is No Fool
 Had a coworker once, he worked in an office but was super handy. He also had a kid. Way it works in my country, when you wish to study at the Uni, you sit for tests and then fill a list of departments you would wish to go into, first being your favourite and descending.
Had a coworker once, he worked in an office but was super handy. He also had a kid. Way it works in my country, when you wish to study at the Uni, you sit for tests and then fill a list of departments you would wish to go into, first being your favourite and descending.
Well, according to how everyone did and last year's results, he was probably going to a department far from home, but that would only be definite the following couple months. Kevin was no fool, though. He knew if he went to rent a house in September he had less chances of finding decent housing at a reasonable price for the kid. So he went 2 months early. Found a nice little apartment, paid the deposit, installed appliances, painted walls and bought furniture.
September came along with the results. The kid was accepted at the same department of a different city.
A Kevin And His Wife Try To Walk Into A Cafe
A couple years ago, I worked at a cafe and met my fair share of... interesting people, but this couple takes the cake when it comes to sheer stupidity. For some quick context, the main entrance to the cafe is a door you just have to pull in order to open.
I was cleaning up the coffee machine when I looked out the glass wall to see a man and a woman approach the cafe. The woman tries to push open the door.
It doesn't work.
I figure she just did that classic thing where you're not sure which way the door opens and just try pushing first since it requires less effort than pulling. So I don't think much of it and just get ready for when they enter.
She pushes the door again.
Okay. Maybe she figured the door was just stuck. I mean, that happens every now and then, right?
I'm about to go help when I see the man walk past her with that 'I got this' look on his face. He confidently places his hand on the handle and...
...he pushes.
He looks genuinely surprised and tries again. And again. And again. Each time, he gets more forceful, at one point slamming his shoulder against the glass door. The two are so preoccupied with this door that they don't even notice me staring dumbfounded at them the whole time, other than being, you know, helpful.
Eventually, I figure that if I don't help, they'll either leave or break the door, so I push myself from the counter to go there and help them. That's when they spot an open sliding door on the other side of the cafe, leading to the outside tables, which are very popular at that time of the year, and decide to go around and squeeze past all the guests sitting there and enjoying their meals.
When they finally made it through, it's as if the stars and planets aligned perfectly. They look towards the main entrance to see an old man approach, place a hand on the handle, and... pull the door open with no effort.
It had been an absolutely uneventful day up until that point, so I had to ask a coworker who didn't witness this to handle them, and I just walked into the back to laugh.
Read one a few years ago where someone had to go out and show them how to walk through the opening to the store (in a mall). They kept standing at the window as if it would somehow magically open. They even stepped to the large opening and talked to the clerk and asked how to get in, clerk told them to just walk in.
Doctor's Son Doesn't Understand Diseases.
I was in high school during the start of the AIDS scare. I was the one most students asked for advice on random science issues. So one day my friend who is the son of a doctor asked me "if you have AIDS and you have sex with a girl who doesn't have AIDS then some of the AIDS leaves your body, so if you do that enough can you cure yourself of AIDS".
I was in high school during the start of the AIDS scare. I was the one most students asked for advice on random science issues. So one day my friend who is the son of a doctor asked me "if you have AIDS and you have sex with a girl who doesn't have AIDS then some of the AIDS leaves your body, so if you do that enough can you cure yourself of AIDS".
I tried explaining how diseases work, how viruses multiply inside the body, and how jacking into a toilet removes the same amount of AIDS (or any other virus) from your body as having sex. But he didn't seem convinced.
He also was at the time considering studying medicine and had exam results that were in the range to make that possible. He scored higher than me in the science exams, which was partly because I wanted to study Computer Science at university and knew that I didn't have to try hard to get sufficient marks for that but also partly because he was getting really good marks in science subjects - including biology!
How someone can get good marks in high school biology and not understand how diseases work remains a mystery to me to this day. I have considered this matter over the last 35 years and still can't work it out.
The interesting thing here is that there's actually a sort of sensible logic behind it - I have something, and if I give it to you I'll have less of it. Even without understanding the underlying process a bit of thought would probably reveal the flaw in the thinking, but that doesn't mean it wasn't a fairly straightforward if P then Q conditional statement.
Airplane Kevin
This was a few years ago, so details might be a bit hazy.
I was returning home from a trip that I cut short due to a family health emergency. The flight was pleasant, but I was in a bad place mentally. I did what I usually do in situations like that and kept to myself, saying few words. I plugged in my headphones and started to listen to some podcast during the two hour flight.
Over the sound of the podcast, I heard someone speaking loudly in a pretentious nasal voice talking. I pulled out my earbuds and heard a guy arguing with a flight attendant about how he had asked for something several times but didn’t get it. I didn’t really care and tried to ignore him but he kept going, asking the flight attendant for her name and telling her that the airline company must hear about it. I don’t remember what he wanted, but it was some kind of drink they didn’t have available for some reason.
I returned to my podcast and raised the volume. Ten minutes later, by the podcast timer, he was still ranting in his annoyingly pretentious way about professionalism, respect and giving customers what they want. I switched to some rock music to drown him out, and saw the captain coming over to talk to him. He was flailing his arms around like spaghetti.
My worry about my hospitalized grandmother gave way to anger and I started fantasizing about all the different ways I would shut him up. The captain walked away with a frustrated look on his face, and the flight attendant started serving the other passengers and ignoring his attempts to stir up trouble. I think they got him some alternative drink which he never touched.
We landed, and I put my earbuds away to get ready to leave. He was first in line by the airplane door and I was right behind him. The door opened and an airport security guard was standing there to escort him through the tube. I followed, and by the end of the tube a higher ranking guard was waiting for him. He stood blocking the way out, and I saw that other passengers behind me were fed up with this guy who never shut up for more than half of the flight time. He was arguing about how terrible the crew and service was, and how he never had service this bad. He kept saying he needs to leave now because his family was waiting for him or some similar non-reason reason.
My anger was starting to boil. Should I shove him? Bang my pulling bag onto his leg? Punch him in the back? Would everybody clap? I had to head straight to the hospital, and everyone behind me had places to go. I’ve heard many stories about people like him online, across many different channels. Nobody would feel bad for them. But this wasn’t only about them, it was also about who I am and what kind of person I want to be.
I took a couple of deep breaths to calm down as he was telling the guards how to do their jobs, and with the most aggressive tone I could come up with despite my stress and exhaustion spoke up. “Get the f**k out of my way.”
That F bomb was enough to stun him since everyone else was following a code of conduct required by their jobs, and for the first time since I noticed him he had nothing to say. The guards took advantage of his silence and started to move him away, hopefully to some back office where he will be delayed for a few hours.
I left the airport and headed home for a quick shower and a change of clothes before going to the hospital. My thoughts kept going back to that entitled guy and how he thought he could be a pretentious and rude guy with people whose jobs require them to be polite. Politeness never works with them, and sometimes meeting someone who thinks they’re scum is the wake up call they deserve.
Coworker's Stolen Car
 My coworker whose name isn't kevin but for the sake of this sub Reddit I'll stick with it, had his car stolen a week before last week. It's mostly focusing on his wife which I'll dub as Kevinetta.
My coworker whose name isn't kevin but for the sake of this sub Reddit I'll stick with it, had his car stolen a week before last week. It's mostly focusing on his wife which I'll dub as Kevinetta.
Some backstory: Kevin got a rent to own car about a month ago. Skipping to around Friday of the week prior, he was dropped off at work so Kevinetta could use the car for whatever. At about 12pm central, he gets a call from his wife that the cars been stolen. He freaked out and tried to figure out what was going on.
The story as it was laid out for me is this: Kevinetta is a Xanax addict. She'd had someone she didn't know DRIVING HER CAR. She and this person drove to a convenience store and Kevinetta got out, leaving the stranger in the car. They of course stole the car. Police were called and the car renting company has trackers in their cars so the plan was to wait till Monday to track the car that way with police involvement.
Barely two days LATER: Kevin was driving in a friends car to go to his bank to empty his accounts as he'd left his wallet in the stolen car. The woman who'd stolen the car STARTED DRIVING BEHIND MY COWORKER. honking at him and everything. The car pulls into a local business parking lot and my coworker used his friend's car to block his car into the parking space. He got to the drivers window, pulled out his car keys and started to pull the woman out as she's wide eyed and stammering "I was looking for kevinetta! I swear!"
There was guys in my coworkers car with the woman, immediately coming to her defense till they realize what's going on.
Police get called by the business owner and they find all. Of. The. [Illegal substances]. On this woman. My coworker got his car back with only a broken window and the woman and guys got all kinds of charges. They'll be away in prison for awhile.
My Coworkers A Kevina
Let's keep this short and simple. For every 100$, 50$ at my work we run it through a special safe, if it's fraudulent claim we don't have money for change(even if we do), if it's real, dish out the change. Onto the story
I was working with Kevina and the situation went like this
"Kevina when someone pays with a 50$ bill, we need to verify it." As in, pass it through the safe, is practice.
"Oh no, I typed it in the computer, I was just giving her change." I internally face-palmed but I gave up. It was a real fifty btw so it didn't matter.
Later, I got a 50 myself and decided to call her over:
"What's the matter? Do you need change for the 50?"
"No, Kevina, I'm showing you what I meant when I said you need to process it first."
"So you have enough for the change?"
Yes Kevina. Yes. I do.
Kevin/Kevina Entering The Workforce
I used to work in logistics for a major sportswear company. In this position I talked to all departments and because any manager or lead in a department was too busy with "big picture issues" tied to any event they dumped getting everything there to the new hires, usually somebody fresh out of college.
In regards to the actual move, I did all the work on the actual transportation arrangements. All I needed were some deadline dates and of course pick up and delivery locations. Because the people were fresh out of college they had to overthink everything and make a major production of it all. A few weren't too bright and I had to be sure to get all the correct information, but it usually wasn't a problem I just tried my best to help them so they could focus on the event. One woman though was so incompetent just getting the basics was near impossible.
She calls me up and says she needs to get a shipment of t-shirts to our in-house screen printer. OK, this is an easy one.
Me: Sure thing Kevina, just let me know where to pick up at and I'll get this going.
Kevina: What do you mean?
Me: Where do I need to pick up the t-shirts that need to be screened?
Kevina: What do you mean?
Me: Where will the truck need to pick up the t-shirts at that need to be sent to the screen printer.
Kevina: I don't know. Would that be [name of company]
Me: If that's where the t-shirts are that need to be screened, yes.
Kevina: I'm not sure what you're asking.
Me: I just need the location where the t-shirts are so I know where to send a truck to pick them up.
Kevina: What do you mean?
This went on for a few more minutes, she even got upset and screamed at me that she was sorry for wasting my time and was going to hang up. I somehow calmed her down and trying a new approach found out who the project was for, then offered to call them to get this sorted out. That was a short email and I had everything I needed in the response.
T-shirts got picked up and screened in plenty of time for the event, I never spoke to Kevina again and think she only lasted a couple months.
Toddler Kevins And Ice
 Today...I (20F)was reminded of the day...I did some antics...where I could be deemed a Kevin.I thought you'd all appreciate it.
Today...I (20F)was reminded of the day...I did some antics...where I could be deemed a Kevin.I thought you'd all appreciate it.
Now remember i was 7 , so my brother who was my partner in crime must be 5ish. So we live in India , where power outages and hot summers prevail.
So, imagine this scenario: It's a blazing hot summer day, and the power decides to take a vacation faster than a cheetah sprinting on hot sand. My dad, being positively overheated, decides to rip off his shirt and drench the bed with some ice-cold water before plopping down like a roasted potato , in the afternoon around 3 , the lights went out which means my dad , opened the windows to create an air flow. But that wasn't quite enough to cool him down. No, sir. He had to ramp up the drama and turn my brother and me into his personal fans.Deada*s , using napkins to fan my father.
My toddler self thought what else is also cold? ICE...You see where this is going.We approached our dad with the brilliant plan of using ice trays as a makeshift cooling system. To our surprise, he agreed, either he was overheated and thus dizzy or probably thought of it as a joke and we being dimwits we are excitedly laid the ice trays on his belly. I mean, what could possibly go wrong, right? Let's just say, the room suddenly went from hot to frozen in a split second. Picture the surprise on his face as he shot up, yowling like a scalded cat. But once he recovered, he couldn't stop laughing at the ridiculousness of it all.
Kevina And The Magical Drum Sticks
Kevina was a nurse (...) from a regional town, now living in the State capital. I knew her via my work friends where there was a small contingent of refugees from said town (she'd tried out at the job but was refused and remained on the fringe of the group), more power to them for running away from the farm.
There were some odd things about her but not my circus, not my monkeys. She once complimented me on how nice my guitar was to play, rather shocking me as I'd left it at a mutual friend's place, not really intending anyone else to touch it.
She once caused a bit of a scene when some plan involving her driving somewhere when amiss as she'd let her registration expire the day before, not driving on expired rego was absolutely genius on her behalf, letting it expire when she had a job and all was what was dumb.
One example of her odd behaviour was getting in someone's bed naked with her boyfriend in someone else's share house (OK?), leaping up in the middle of the night and running through the rooms still butt-naked (...OK?) and then reacting in horror when she found herself the centre of attention when she finally hit the kitchen, where everyone else was ( ... what?). Running around naked in someone else's house, sure, why not, but do it in style, for f'sake.
Anyway, on a whole different occasion there was a party at another share house. My friend had gotten his drum kit there but failed to bring any sticks. I had some as the kit had lived in my living room once, so I caught the bus there and in front of the assembled guests produced them from my sleeve as a magician would with a bouquet of flowers. Amazing ...
Some months later, possibly in the order of a year, she saw me again and asked "Do you still have those sticks ... because I want to test out this girl ..."
I had to disappoint her, as I was not a human Pez dispenser. If I could exude odd things from my person it'd probably be gold bars or moon dust, drum sticks I'd go to the shop and buy ... they cost about a dollar apiece.
Kevin The Culinary Artist
Some background: My wife and I love cooking. It's one of our favorite hobbies. We cook together at least once a week, and generally we make enough to have leftovers. We have very few microwave meals in the house.
Enter Kevin. Kevin is a friend of a friend who I had casually known for about 4 years. He had recently lost his job, couldn't afford his apartment and needed a place to crash while he got back on his feet. Feeling generous, my wife and I offered our guest room for a few weeks. On his first day with us, my wife and I made a meal together for all of us. Kevin was inspired(?) by our lifestyle and told us "Oh yeah! I love cooking too! Let me make breakfast for you tomorrow!". This was the start of a kitchen catastrophe.
Kevin tried to make fried eggs by putting an 8 inch skillet on the highest possible heat. The flames were actively burning the plastic handle. My house smelled like electrical fire for days.
Kevin noticed the smell the next day and insisted that my dog had s**t in the house somewhere.
Kevin needed to be taught not to keep his fingers in the path of a knife. He somehow consistently kept the flat side of vegetables facing up when chopping. We quickly stopped letting him cut anything.
Kevin could not fathom the concept of pre-heating.
Kevin thought the packaged ground beef in my fridge was noodles.
Kevin was vehemently against leaving the fridge open for any reason. He said that my milk would go bad because I had the door open for 3 minutes while restocking after a grocery run.
When my wife and I were at work, Kevin tried to make grilled chicken using pre-seasoned chicken breasts, and used a youtube tutorial (+1 for effort). He put the chicken directly on my gas stove because he thought it was the same as a grill.
Kevin kept suggesting that our little herb garden would be great for growing pot. I don't know much about marijuana, but I'm pretty sure you can't grow it in a tiny pot like that.
I walked Kevin through baking cookies from a pre-made dough. We watched TV while waiting. When the timer went off, I told him to get the cookies out. He came back to the living room and said "I'll let it cool down". He had tried to get the pan out with his bare hands, and left it in the hot oven to cool down.
I told Kevin that microwaving an egg would make it explode. This excited him. While I was at work, he microwaved an egg. It exploded.
The whole time he kept pretending like he knew what he was doing, and was "just making sure" with his questions. This was over the span of about 5 days. We basically didn't let him in the kitchen after this point. We learned after he'd left our place that he had been in a long-term relationship in which his girlfriend did all the cooking and meal prep. What I don't understand is why he felt he needed to lie. If he had said "I don't know much about cooking, but it looks like fun and I'd love to join you", we wouldn't have had a problem. Some bonus Kevinisms:
Kevin hounded us asking if he could eat our share of the leftovers. (We usually made enough for food for 3 people while he was staying with us) This wasn't stupid. Just rude.
Kevin called all streaming "netflix". E.g. "Game of Thrones is on Netflix on HBO Max"
I Think I Met A Kevanjela
My friend and I went to a local theater show. Six people to a table: two adorable gay fellows, my friend and I, and two older woman friends.
At one point Kevanjela randomly starts telling us about how she just got a new SUV. She tells us only her friend (friend beside) isn't surprised when she tells people that this is the third car she's had in less than a year. "Wow.. that's.. a lot..", we say. Kevanjela then tells us that her husband is Boberino and he bought each suv for her. There's one city counsellor who owns half the town who's name is Boberino and is very rich and in everyone's business. This is a very small town and he does not have that common of a name. So of course this makes sense that she's been gifted her third SUV in under a year. They've been upgrading. She's rich and married to Boberino.
My friend Lola says she's actually been discussing with Boberino on facebook messenger about some fundraising ideas she's had for one of Boberino's businesses that everyone knows he owns. Kevangela nods and asks to hear more. Lola and I know of Boberino well and as a city counselor he is very active in facebook anyways. So this makes logical sense. Kevangela agrees.
An hour later Kevangela pulls my friend Lola aside and asks to speak with her privately. I keep watching the show. Kevangela wanted to know why my friend was private messaging with her husband and if they were having an affair together.
Kevangela completely ignored the fact that my friend was talking about a business the famous Boberino owns and just assumed it was her husband even though no one would think of her random Boberino husband who shares a name with the owner of half the town.
Kevangela was so appalled at my friend for confusing her. As soon as Kevangela heard my friend was talking to Boberino, Kevangela immediately started texting her husband accusing him of cheating on her and did not think to first ask my friend, are you talking about my husband, Boberino Nobody?
Apparently Boberino was on his way at that very moment to the theater with their kids in tow to try and prove to Kevangela that he wasn't having an affair with my friend Lola.
I wasn't privy to the conversation Kevangela and her husband Boberino had once he got there, but i imagine it was something serious as she never came back inside..
This is... a mess. But I'm pretty sure in addition to Kevangela the friend deserves to be Kevilola, seeing as she didn't bother to confirm that they were talking about Boberino Somebody rather than Boberino Nobody. And that is a sentence I will surely never use again.
Louie Is A Kevin
Kevin was the adult son of an elderly woman my mate had the misfortune of "working" for, described as the curly headed gangster in The Simpsons. She'd worked a series of really quite c****y subsistence jobs, cleaning, house and pet sitting, this deal was she'd be all live-in carer for NO wages, but would be given the woman's old car on the happy occurrence of her death. One day the phantom son showed up and they both tried to double team my friend, merely make a false declaration to the welfare body that he'd really and secretly been living there as her carer for years and was thus owed tens of thousands in allowance back pay. She declined and was later told by the visiting nurse she too had been encouraged to submit a small VERY LARGE fraudulent declaration on his behalf. Need I add she was then fired with no car or wages of any sort? So Kevin pulled his master stroke and explained why she should break the law to help him rob the government.
"I have to go to jail next week!"
Had to quit halfway through because the authors of these posts were getting pretty bad at writing. Does no one understand basic grammar and spelling anymore?
There's some major irony in having so many poorly written stories in a collection of stories about stupid people.
Load More Replies...I had a coworker who had a daughter who was book smart, but simple things would trip her up. For example, a couple of days after 9/11, this girl and a friend were watching the news, when footage from the attacks was being played. The poor girl became agitated and distraught, crying out that it happened again and "how could the government allow this to happen twice". Her parents heard her freaking out, and thinking there had been another attack somewhere else, flew into the living room only to see the news replaying the footage she just saw.
Had to quit halfway through because the authors of these posts were getting pretty bad at writing. Does no one understand basic grammar and spelling anymore?
There's some major irony in having so many poorly written stories in a collection of stories about stupid people.
Load More Replies...I had a coworker who had a daughter who was book smart, but simple things would trip her up. For example, a couple of days after 9/11, this girl and a friend were watching the news, when footage from the attacks was being played. The poor girl became agitated and distraught, crying out that it happened again and "how could the government allow this to happen twice". Her parents heard her freaking out, and thinking there had been another attack somewhere else, flew into the living room only to see the news replaying the footage she just saw.

 Dark Mode
Dark Mode 

 No fees, cancel anytime
No fees, cancel anytime 














































